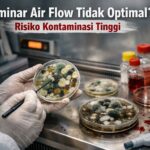
Laminar Air Flow Tidak Optimal? Risiko Kontaminasi Tinggi

๐ฌ Kenapa Service Alat Laboratorium Tidak Boleh Ditunda?
Banyak laboratorium baru melakukan perbaikan saat alat sudah benar-benar rusak total.
Padahal, dalam banyak kasus, alat sebenarnya sudah menunjukkan tanda-tanda kerusakan sejak awal.
Jika tanda ini diabaikan, maka risiko yang terjadi bisa sangat besar, mulai dari hasil uji tidak akurat hingga gagal audit.
๐ Untuk memahami dampaknya secara menyeluruh, baca juga:
Perbaikan Alat Laboratorium: Jangan Tunggu Rusak Total, Ini Risiko dan Solusinya
โ ๏ธ 5 Tanda Alat Laboratorium Harus Segera Diservice
๐ฅ 1. Suhu Tidak Stabil atau Tidak Sesuai
Jika alat seperti oven, furnace, atau waterbath menunjukkan suhu yang naik turun atau tidak sesuai setting, ini adalah tanda awal kerusakan.
๐ Baca:
โ๏ธ 2. Hasil Pengukuran Tidak Akurat
Jika neraca atau alat ukur lainnya menunjukkan hasil yang berubah-ubah, maka kemungkinan besar sudah tidak akurat.
๐ Baca:
- Neraca Tidak Akurat
๐ 3. Alat Tidak Berfungsi Normal
Contoh:
- hotplate tidak panas
- stirrer tidak berputar
- incubator tidak bekerja
๐ Baca:
- Hotplate Tidak Panas atau Tidak Berputar
- Incubator Tidak Berfungsi
๐งผ 4. Lingkungan Kerja Tidak Terjaga
Jika laminar air flow atau fumehood tidak bekerja optimal, maka risiko kontaminasi dan bahaya kerja meningkat.
๐ Baca:
- Laminar Air Flow Tidak Optimal
- Fumehood Bermasalah
โ ๏ธ 5. Muncul Error atau Bunyi Tidak Normal
Jika alat mulai:
- muncul error
- berbunyi tidak normal
- respon lambat
๐ ini tanda bahwa komponen internal mulai bermasalah.
๐จ Dampak Jika Tanda Ini Diabaikan
Jika tanda-tanda di atas tidak segera ditangani, maka dapat menyebabkan:
- hasil pengujian tidak valid
- kerusakan alat lebih parah
- biaya perbaikan lebih besar
- gangguan operasional
- risiko gagal audit
Dalam standar ISO/IEC 17025, kondisi alat menjadi faktor penting dalam memastikan validitas hasil.
๐ ๏ธ Solusi: Lakukan Service Sejak Dini
Langkah terbaik yang dapat dilakukan:
โ Pengecekan Berkala
Untuk mendeteksi masalah sejak awal
โ Service Alat Laboratorium
Dilakukan oleh teknisi berpengalaman
โ Kalibrasi Rutin
Untuk menjaga akurasi alat
๐ผ Layanan Perbaikan Alat Laboratorium
Kami menyediakan:
- pengecekan & diagnosa alat
- perbaikan berbagai alat laboratorium
- kalibrasi alat
- maintenance rutin
Didukung tim teknis berpengalaman dalam menangani berbagai jenis alat laboratorium.
๐ Konsultasi & Diagnosa Awal GRATIS
Kami telah membantu berbagai laboratorium dalam menjaga performa alat dan kesiapan audit.
Jika Anda menemukan tanda-tanda seperti di atas:
๐ jangan tunggu sampai rusak total
Anda dapat mengirimkan foto atau video alat untuk diagnosa awal tanpa biaya.
๐ Jadwalkan Pengecekan Sekarang
Kerusakan kecil yang diabaikan dapat berkembang menjadi masalah besar.
๐ Segera lakukan pengecekan dan perbaikan.
Tim Teknis Solusi ISO Produktivitas siap membantu Anda.
๐ WhatsApp: 08112639648
๐ Website: solusiisoproduktivitas.com
๐ Kesimpulan
Mengetahui tanda-tanda awal kerusakan alat laboratorium adalah langkah penting untuk mencegah kerugian yang lebih besar.
Service sejak dini bukan hanya menghemat biaya, tetapi juga menjaga kualitas hasil pengujian dan kesiapan audit.